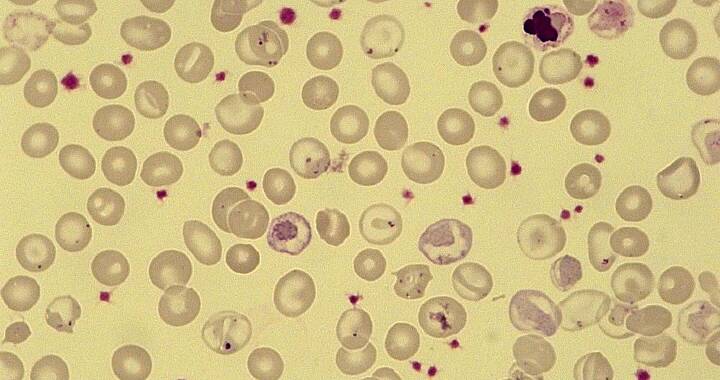
Helles Gelb mit Blutkörperchen auf der vereinzelt rote Punkte zu erkenneen sind, die auf eine Erkrankung hindeuten.

Wir betreuen Patientinnen und Patienten mit nicht-bösartigen Bluterkrankungen. Wir bieten Beratung, Diagnostik und gegebenenfalls Therapie bei Verdacht auf Erkrankungen aller drei Zellreihen:
Anämien (Rote Zellreihe, Erythrozyten),
u. a.:
- Eisen- oder Vitamin B 12-Mangel,
- Enzymdefekte der Erythrozyten (z. B. Glucose-6-Phosphat-Dehydrogenase-Mangel)
- Membrandefekte der Erythrozyten (z. B. Sphärozytose)
- Autoimmun-Hämolyse (AIHA)
- Hämoglobinopathien wie Sichelzell-Krankheit oder Thalassämien
- Angeborene oder erworbene Bildungsstörungen des Knochenmarks (z. B. Diamond-Blackfan-Anämie, Transitorische Erythroblastopenie des Kindesalters)
Weiße Zellreihe (Leukozyten), z. B.:
- Autoimmun-Neutrozytopenie
- Zyklische Neutropenie des Kindesalters
Blutplättchen (Thrombozyten), z. B.:
- Immunthrombozytopenie (ITP)
- Angeborene Bildungsstörungen
- Thrombozytopathien
Im Rahmen eines umfassenden Vorsorge- und Therapiekonzeptes betreuen wir in unserer Spezialsprechstunde kontinuierlich Patientinnen und Patienten, die regelmäßig Bluttransfu-sionen benötigen oder aufgrund ihrer Erkrankung einen erhöhten Betreuungs- und Präventionsbedarf haben (z. B. Patienten mit Sichelzellkrankheit, Thalassämia major, Diamond-Blackfan-Anämie oder Sphärozytose). Im Rahmen des seit 2020 durchgeführten Neugeborenen-Screenings auf Sichelzellkrankheit ist unser Zentrum als primärer Ansprechpartner für Patienten im Regierungsbezirk Schwaben gelistet.
Weitere Links: